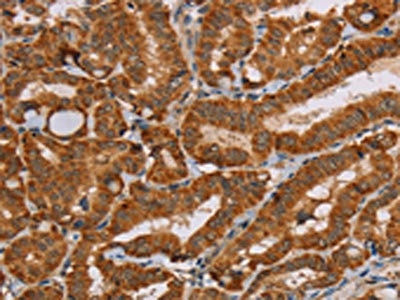

MSR1 Antibody
-
中文名稱:MSR1兔多克隆抗體
-
貨號:CSB-PA194131
-
規(guī)格:¥1100
-
圖片:
-
其他:
產(chǎn)品詳情
-
Uniprot No.:
-
基因名:MSR1
-
別名:MSR1; SCARA1; Macrophage scavenger receptor types I and II; Macrophage acetylated LDL receptor I and II; Scavenger receptor class A member 1; CD antigen CD204
-
宿主:Rabbit
-
反應(yīng)種屬:Human,Mouse
-
免疫原:Fusion protein of Human MSR1
-
免疫原種屬:Homo sapiens (Human)
-
標記方式:Non-conjugated
-
抗體亞型:IgG
-
純化方式:Antigen affinity purification
-
濃度:It differs from different batches. Please contact us to confirm it.
-
保存緩沖液:-20°C, pH7.4 PBS, 0.05% NaN3, 40% Glycerol
-
產(chǎn)品提供形式:Liquid
-
應(yīng)用范圍:ELISA,IHC
-
推薦稀釋比:
Application Recommended Dilution ELISA 1:2000-1:5000 IHC 1:50-1:200 -
Protocols:
-
儲存條件:Upon receipt, store at -20°C or -80°C. Avoid repeated freeze.
-
貨期:Basically, we can dispatch the products out in 1-3 working days after receiving your orders. Delivery time maybe differs from different purchasing way or location, please kindly consult your local distributors for specific delivery time.
-
用途:For Research Use Only. Not for use in diagnostic or therapeutic procedures.
相關(guān)產(chǎn)品
靶點詳情
-
功能:Membrane glycoproteins implicated in the pathologic deposition of cholesterol in arterial walls during atherogenesis. Two types of receptor subunits exist. These receptors mediate the endocytosis of a diverse group of macromolecules, including modified low density lipoproteins (LDL). Isoform III does not internalize acetylated LDL.
-
基因功能參考文獻:
- The expression of CD204 in tumor-associated macrophages is associated with the aggressiveness of lung adenocarcinoma. PMID: 29850577
- Decreased expression by OxLDL in PMA-differentiated THP-1 macrophages. Increased expression in plaque vs. nonplaque lesion areas in human carotid endarterectomy specimens (correlated with CD36 expression). PMID: 18827892
- Cytokine abnormality induced by SRA(+) cells playS an role in tissue injury, and platelet emboli or contraction band necrosis might have been the leading cause of death in our SUDI cases. PMID: 21790861
- TGM2 has a role in macrophage differentiation via mechanisms involving CD14 and SR-AI receptors. PMID: 27378395
- study demonstrates the elevated SR-A expression on cell surface contributes to increased susceptibility to Adenovirus serotype 5 (Ad5) infection into CD14+ monocytes; SR-A-mediated Ad5 entry, TLR3 signaling activation and acLDL accumulation in monocytes/ macrophages synergistically trigger the inflammatory responses and innate immunity against Ad5 infection PMID: 29680370
- SR-A1 expression in 136 human gliomas was positively correlated with tumor grade (P<0.01), but not prognosis or tumor recurrence PMID: 27367025
- The results reveal marked differences between afferent and efferent ymphatic endothelial cells and identify molecules on lymphatic vessels. Further characterizations of Siglec-1 (CD169) and macrophage scavenger receptor 1 (MSR1/CD204), show that they are discriminatively expressed on lymphatic endothelium of the subcapsular sinus but not on lymphatic vasculature of the lymphatic sinus PMID: 27601677
- High density of CD204(+) tumor-associated macrophages was associated with the aggressive behavior and worse survival of gastric cancer. Low density of CD204(+) TAMs was associated with infection of EBV, which may explain the favorable outcome of EBV-associated gastric carcinoma. PMID: 27342912
- SR-A1 suppresses lung cancer metastasis by downregulating SAA1 production in tumor-associated macrophages (TAM). PMID: 28202524
- PTX2 was identified PTX2 as a novel partner for FX, and both proteins cooperated to prevent their SR-AI-mediated uptake by macrophages. PMID: 28213380
- we found that higher percentages of circulating CD14+CD204+, CD14+CD163+CD204+ M2-like monocytes were significantly associated with TNM stage, lymph node metastasis, and histological differentiation. PMID: 28639912
- Identifying N-linked glycan moiety and motifs in the cysteine-rich domain critical for N-glycosylation and intracellular trafficking of SR-AI and MARCO. PMID: 26892079
- Findings suggest that CD204+ Mphis might play detrimental protumoral roles and represent the predominant Mphi phenotype in human bladder cancer. PMID: 26001293
- The P275A Polymorphism in the Macrophage Scavenger Receptor 1 Gene is not associated with Prostate Cancer Risk. PMID: 26225686
- Cyr61 promotes CD204 expression and the migration of macrophages via MEK/ERK pathway in esophageal squamous cell carcinoma PMID: 25620088
- miR-29a promotes scavenger receptor A expression by targeting QKI during monocyte-macrophage differentiation. PMID: 26056009
- Heptapeptide XD4 activates the class A scavenger receptor (SR-A) on the glia by increasing the binding of Abeta to SR-A, thereby promoting glial phagocytosis of Abeta oligomer in microglia. PMID: 24718459
- The truncating variant Arg293X in the gene encoding SRA-I/II was associated with reduced lung function and with increased risk of COPD among men, as well as among alpha1-antitrypsin MZ and superoxide dismutase-3 E1I1 heterozygotes. PMID: 25186548
- monomeric collagen type I via CD204 induces phospho-Akt expression shifting alveolar macrophages to the profibrotic M2 type. Innate immune responses induced by collagen monomers might perpetuate pulmonary fibrosis. PMID: 24278429
- High CD204 expression is an independent predictor for both overall and disease-free survival in pancreatic ductal adenocarcinoma. PMID: 24839953
- High CD204 expression is associated with metastasis and recurrence in non-small-cell lung cancer. PMID: 24419414
- There was a significant negative correlation between the number of CD163(+), CD204(+) or CD206(+) alveolar macrophages. PMID: 24498098
- rs6966 (3' UTR of PPP1R13L, chr 19q13.32, P = 4.55 x 10(-9)) and rs414580 (intron 2 of MSR1, chr 8p22, P = 6.09 x 10(-8)) were significantly associated with ALL. PMID: 24604828
- Our data suggest that inefficient folding of SR-AI variants with truncated SRCR domain was recognized by the endoplasmic reticulum associated degradation which leads to the immature N- glycosylation and intracellular retention PMID: 23915271
- CD204 is a useful marker for TAMs contributing to the angiogenesis. PMID: 23648122
- MSR1 to be a critical component of a TLR3-mediated pattern recognition receptor response that exerts an antiviral state in both infected and uninfected hepatocytes, thereby limiting the impact of HCV proteins that disrupt IFN signaling in infected cells PMID: 23717201
- In this review, we showed that SR-A and MARCO trigger intracellular signaling, modulating pro-inflammatory and microbicidal activities of macrophages. PMID: 22470185
- This review demonstrated that class A SR and MARCO are major pattern recognition receptors mediating opsonin-independent phagocytosis. PMID: 22470186
- Data suggest that pulmonary metastasis is corrected with levels of Geminin, cleaved caspase-3, CD44, E-cadherin, epidermal growth factor receptor, and CD204 in cancer cells within permeated lymphatic vessels. PMID: 22429811
- The results of this study found that SR-AI/II was highly expressed on the surface of foamy macrophages in MS lesions. PMID: 23334594
- We identified in a Chinese population a functional polymorphism in SR-A linked to lung cancer risk. In vivo and in vitro studies demonstrated that SR-A may negatively modulate lung cancer growth and angiogenesis by regulating MMP9 production. PMID: 22878280
- Through regulating PI3K/Akt and ERK activity, PKCdelta affects SR-A and CD36 expression and foam cell formation. PMID: 22687273
- In patients with symptoms of acute coronary syndrome the amount of CD36 and MSR1 mRNA in circulating monocytes, as well as the density of both receptors on the cells surface was significantly higher. PMID: 22763563
- Identified a novel peptide antagonist selective for SR-AI which could be a valuable tool in SR-AI targeted imaging of atherosclerotic lesions. PMID: 22282357
- Msr1 suppresses leukemia stem cells and chronic myeloid leukemia development. PMID: 21596859
- Interleukin 10 abrogated the oxidized low density lipoprotein-induced SR-A mRNA expression by 50.2+/-3.9% and its protein by 45.6+/-1.9%. PMID: 21658363
- Pattern recognition scavenger receptor CD204 attenuates Toll-like receptor 4-induced NF-kappaB activation by directly inhibiting ubiquitination of tumor necrosis factor (TNF) receptor-associated factor 6. PMID: 21460221
- novel property of SR-AI as a complement receptor for iC3b-opsonized bacteria that can elicit cell signaling PMID: 21203986
- IFNalpha priming up-regulated the expression of SR-A in human monocyte/macrophages, leading to increased lipid uptake and foam cell formation. PMID: 21280004
- Stromal macrophage expressing CD204 is associated with tumor aggressiveness in lung adenocarcinoma. PMID: 20802348
- human protein S can inhibit the expression and activity of SR-A through Mer RTK in macrophages, suggesting that human protein S is a modulator for macrophage functions in uptaking of modified lipoproteins PMID: 18922854
- SRA-1 is an endocytic receptor for hepatitis C virus non-structural protein 3 in dendritic cells. PMID: 20338659
- Decreased infiltration of macrophage scavenger receptor-positive cells in initial negative biopsy specimens is correlated with positive repeat biopsies of the prostate. PMID: 20384632
- Observational study of gene-disease association, gene-environment interaction, and pharmacogenomic / toxicogenomic. (HuGE Navigator) PMID: 20628086
- CD36 and SR-A play an important role in platelet-induced foam cell formation from CD34(+) progenitor cells PMID: 20414830
- Clinical trial of gene-disease association and gene-environment interaction. (HuGE Navigator) PMID: 20379614
- The MSR1 association with COPD susceptibility, COPD-related measures of lung function, and abnormalities of macrophage function may account for significant COPD morbidity. PMID: 20081102
- Our findings corroborate the involvement of ELAC2, MSR1, and RNASEL in the etiology of prostate cancer even in individuals without a family history. PMID: 20086112
- Observational study of gene-disease association, gene-gene interaction, and gene-environment interaction. (HuGE Navigator) PMID: 20086112
- Macrophage SR-A is found to recognize exchangeable apolipoproteins (Apo)A-I and ApoE in both lipid-free and lipid-associated form, suggesting the shared amphipathic alpha-helix as a potential recognition motif. PMID: 19911804
顯示更多
收起更多
-
相關(guān)疾病:Prostate cancer (PC); Barrett esophagus (BE)
-
亞細胞定位:Membrane; Single-pass type II membrane protein.
-
組織特異性:Isoform I, isoform II and isoform III are expressed in monocyte-derived macrophages. Isoform I and isoform II are expressed in the liver, placenta and brain.
-
數(shù)據(jù)庫鏈接:
Most popular with customers
-
-
YWHAB Recombinant Monoclonal Antibody
Applications: ELISA, WB, IHC, IF, FC
Species Reactivity: Human, Mouse, Rat
-
Phospho-YAP1 (S127) Recombinant Monoclonal Antibody
Applications: ELISA, WB, IHC
Species Reactivity: Human
-
-
-
-
-